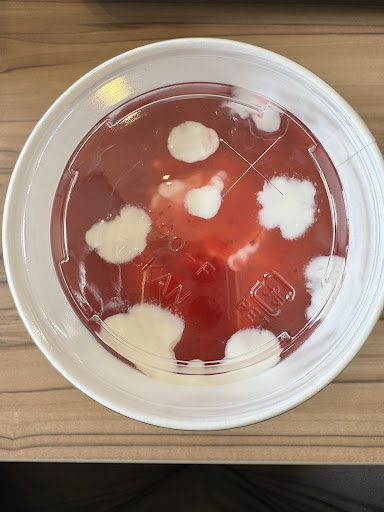
See more posts

MOS BURGER Jimokuji Shop things to do, attractions, restaurants, events info and trip planning

Basic Info
MOS BURGER Jimokuji Shop
Japan, 〒490-1114 Aichi, Ama, 下萱津九反田52
3.8(254)
Closed


delivery
Save
spot
spot
Ratings & Description
Info
attractions: , restaurants: 麺屋りょうま櫻堂, Royal Host Jimokuji, ANETTAI JIMOKUJI, Bon, Katsutoki Jimokuji, Yoshinoya, Kura Sushi Jimokuji, Hanashobu, McDonald's, インドネパールカレーDEVI あま店, local businesses:
 Learn more insights from Wanderboat AI.
Learn more insights from Wanderboat AI.Phone
+81 52-443-1450
Website
mos.jp
Open hoursSee all hours
Thu9 AM - 12 AMClosed
Plan your stay

Pet-friendly Hotels in Ama
Find a cozy hotel nearby and make it a full experience.

Affordable Hotels in Ama
Find a cozy hotel nearby and make it a full experience.

The Coolest Hotels You Haven't Heard Of (Yet)
Find a cozy hotel nearby and make it a full experience.

Trending Stays Worth the Hype in Ama
Find a cozy hotel nearby and make it a full experience.
Featured dishes
View full menu
メンチカツチーズバーガー
※中身が熱い場合がありますので、お気をつけください。
月見フォカッチャ
※中身が熱い場合がありますので、お気をつけください。
モスライスバーガー 金沢カレーカツ
金沢カレーソースを使用しています。(2023年10月15日(水)なくなり次第終了, モスバーガー×日本梨科大学 コラボ企画 協力金沢市)
バーベキュー フォカッチャ
コーンスープ
北海道産コーン使用 (熱々)
Reviews
Live events

Candlelight: 久石譲の音楽の世界
Fri, Feb 13 • 4:45 PM
愛知県名古屋市中区三の丸1丁目1−1, 460-0001
View details

中山道馬籠・妻籠 日帰り少人数ツアー
Thu, Feb 12 • 12:00 AM
名古屋市中村区椿町7, 453-0015
View details

旅行者のための漫画体験コース
Thu, Feb 12 • 1:00 AM
White Heather Industrial Estate, 291/293 S Circular Rd, Saint James, Dublin 8
View details
Nearby restaurants of MOS BURGER Jimokuji Shop
麺屋りょうま櫻堂
Royal Host Jimokuji
ANETTAI JIMOKUJI
Bon
Katsutoki Jimokuji
Yoshinoya
Kura Sushi Jimokuji
Hanashobu
McDonald's
インドネパールカレーDEVI あま店

麺屋りょうま櫻堂
3.9
(173)
Closed
Click for details

Royal Host Jimokuji
3.8
(385)
Closed
Click for details

ANETTAI JIMOKUJI
3.3
(115)
Open until 12:00 AM
Click for details

Bon
4.0
(241)
Closed
Click for details